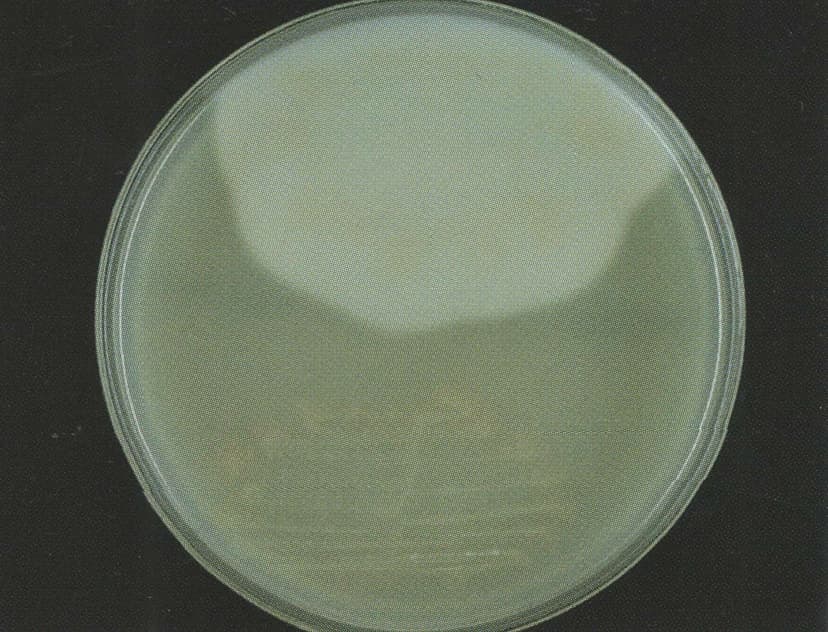
کلستریدیوم دیفیسیل و کلستریدیوم پرفرنجنس بر روی آگار زرده تخممرغ

کلستریدیوم دیفیسیل و کلستریدیوم پرفرنجنس بر روی آگار زرده تخممرغ
کلستریدیوم دیفیسیل و کلستریدیوم پرفرنجنس بر روی آگار زرده تخممرغ، کلستریدیوم پرفرنجنس تولید لسیتیناز کرده و رسوب سفید رنگ تولید کرده (نیمه بالایی پلیت)، در حالی که کلستریدیوم دیفیسیل بر روی محیط رشد کرده اما واکنش ایجاد نکرده است (نیمه پایینی پلیت).